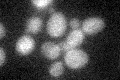
YFL065C
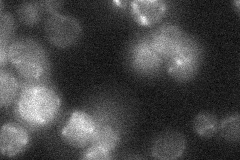
YFL065C
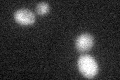
YFL065C
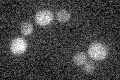
YFL065C

View description
Putative protein of unknown function; induced by treatment with 8-methoxypsoralen and UVA irradiation
Localization:
Intensity:
Fold change:
Significance:
-
C’ GFP library in SD
below threshold18.61 -
N' NOP1pr-GFP in SD

mitochondria43.2282 -
N' TEF2pr-mCherry in SD

missing0 -
N' NATIVEpr-GFP in SD
below threshold14.8967 -
N' TEF2pr-VC and Cyto-VN in SD

#N/A0 -
C’ GFP library in SD+DTT
cytosol18.240.97No -
C’ GFP library in SD+H2O2

cytosol15.460.83No -
C’ GFP library in Starvation Media
cytosol17.160.92No -
C’ GFP library on the background of Pup2-DaMP

N/A -
C’ GFP library on the background of CCT mutant

N/A0N/AYes
